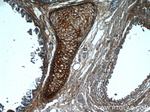
Biglycan Antibody in Immunohistochemistry (Paraffin) (IHC (P))

Search
Proteintech
Biglycan Polyclonal Antibody
{{$productOrderCtrl.translations['antibody.pdp.commerceCard.promotion.promotions']}}
{{$productOrderCtrl.translations['antibody.pdp.commerceCard.promotion.viewpromo']}}
{{$productOrderCtrl.translations['antibody.pdp.commerceCard.promotion.promocode']}}: {{promo.promoCode}} {{promo.promoTitle}} {{promo.promoDescription}}. {{$productOrderCtrl.translations['antibody.pdp.commerceCard.promotion.learnmore']}}
产品信息
16409-1-AP
种属反应
已发表种属
宿主/亚型
分类
类型
抗原
偶联物
形式
浓度
规格
纯化类型
保存液
内含物
保存条件
运输条件
产品详细信息
Immunogen sequence: MWPLWRLVS LLALSQALPF EQRGFWDFTL DDGPFMMNDE EASGADTSGV LDPDSVTPTY SAMCPFGCHC HLRVVQCSDL GLKSVPKEIS PDTTLLDLQN NDISELRKDD FKGLQHLYAL VLVNNKISKI HEKAFSPLRK LQKLYISKNH LVEIPPNLPS SLVELRIHDN RIRKVPKGVF SGLRNMNCIE MGGNPLENSG FEPGAFDGLK LNYLRISEAK LTGIPKDLPE TLNELHLDHN KIQAIELEDL LRYSKLYRLG LGHNQIRMIE NGSLSFLPTL RELHLDNNKL ARVPSGLPDL KLLQVVYLHS NNITKVGVND FCPMGFGVKR AYYNGISLFN NPVPYWEVQP ATFRCVTDRL AIQFGNYKK (1-368 aa encoded by BC004244 )
靶标信息
BGN is a small cellular or pericellular matrix proteoglycan that is closely related in structure to two other small proteoglycans, decorin and fibromodulin. The protein and decorin are thought to be the result of a gene duplication. Decorin contains one attached glycosaminoglycan chain, while this protein probably contains two chains. For this reason, this protein is called biglycan. This protein is thought to function in connective tissue metabolism by binding to collagen fibrils and transferring growth factor-beta. It may promote neuronal survival.
仅用于科研。不用于诊断过程。未经明确授权不得转售。
生物信息学
蛋白别名: Biglycan; bone/cartilage proteclycan 1; Bone/cartilage proteoglycan I; bone/cartilage proteoglycan-I; dermatan sulphate proteoglycan I; PG S1; PG-S1; proteoglycan I precursor; small leucine-rich protein 1A; Small proteoglycan I (biglycan), bone (BSPG1) (bone/cartilage proteclycan 1 precursor); unnamed protein product
基因别名: BG; BGN; BSPG1; DSPG1; MRLS; PG-S1; PGI; SEMDX; SLRR1A
UniProt ID: (Human) P21810, (Mouse) P28653, (Rat) P47853
Entrez Gene ID: (Pig) 397396, (Human) 633, (Mouse) 12111, (Rat) 25181